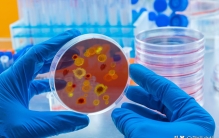

参考消息网9月4日报道 据美国趣味科学网站8月9日报道,抗生素的出现使许多曾经危及生命的疾病变成轻度疾病。不幸的是,细菌能迅速繁殖,并且很容易适应新的基因序列,这使它们能够进化出对救命药物的耐药性,尤其是 ...
2024-9-5 10:46

研究人员早就发现,世界上最脏的东西不是粪便和污泥,而是钱,尤其是纸币。钱币上细菌的真相几年前,香港大学城的一项研究表明,在香港、中国、印度、巴基斯坦、柬埔寨、菲律宾和朝鲜七个亚洲国家和地区的货币中,人 ...
2024-4-27 16:36

它是世界上最大的老鼠,不仅无害,还被称为英雄,你知道它是谁吗
说起老鼠,很多人都会联想到它们对人类的害处,几乎人人都会厌恶它们。但很少有人知道有一种世界上最大的老鼠——非洲巨鼠。与其他我们常见的老鼠不同,这种巨大的老鼠并不对人类造成威胁,相反,它们被大家称为英雄 ...
2023-7-23 14:21

我国目前的法定报告传染病共有40种,按危害程度分为甲乙丙。本次新冠肺炎被定义为乙类传染病,但是按照甲类传染病预防控制措施。甲类传染病还有一个名字:强制管理传染病。根据国家规定,无论是对甲类传染病发生后报 ...
2023-6-16 01:17
自从我们的物种进化成现代形式之前,人类就在与病毒作斗争。对于某些病毒性疾病,疫苗和抗病毒药物使我们能够防止感染并阻止广泛传播,帮助患者康复。但是,要赢得对抗病毒的斗争,我们还有很长的路要走。在最近的几 ...
2023-4-1 04:14

人类的发展史也可以说人类战胜一场场疾病的奋斗史,对人类影响最大的莫过于恶性传染病,也就是瘟疫瘟疫小的影响一个村落、大的毁灭一个国家纵观全球历史,有十大瘟疫,令世人恐慌,有的甚至到现在仍然存在。NO.10 雅 ...
2023-2-14 15:30